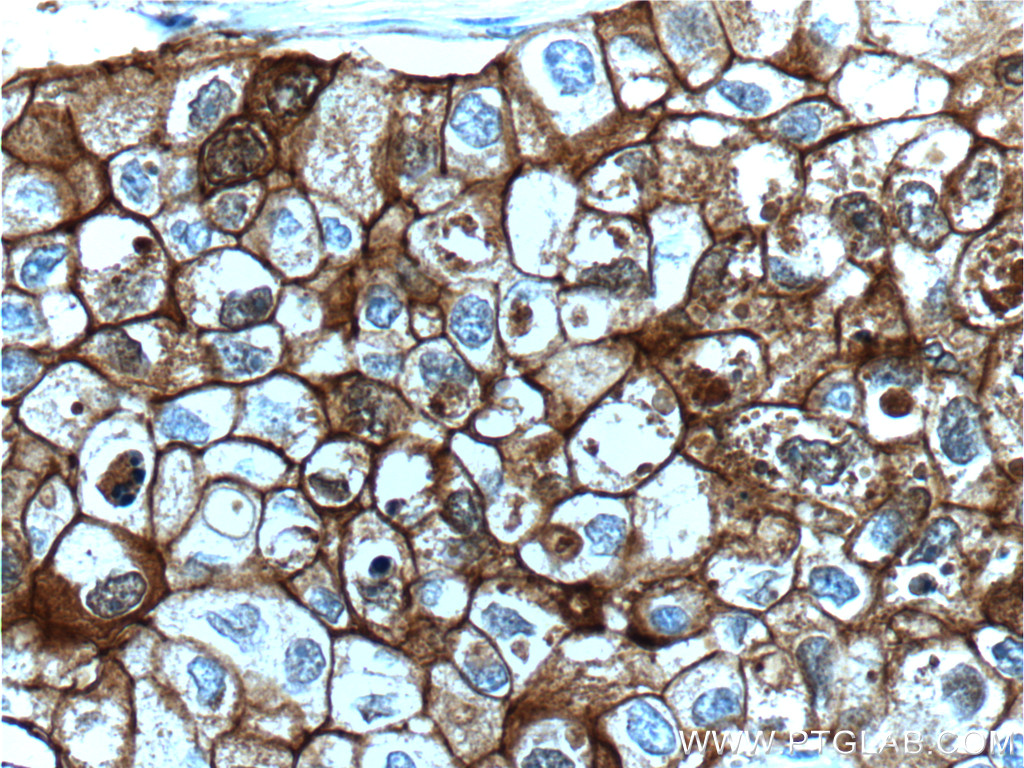
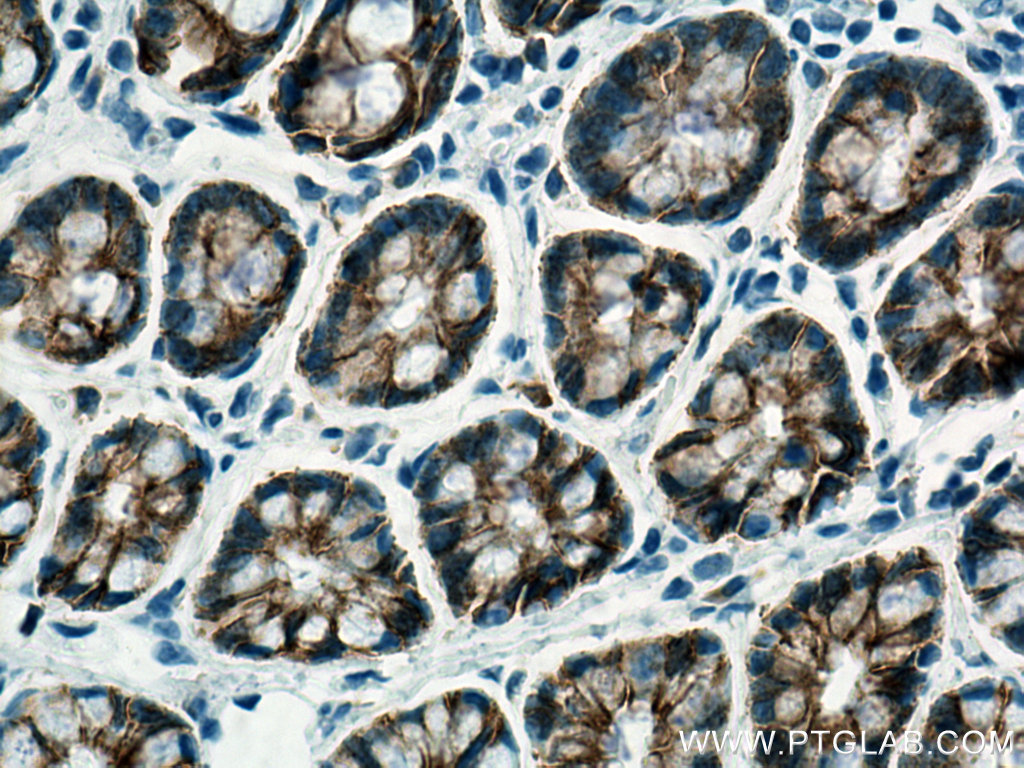

验证数据展示
经过测试的应用
| Positive WB detected in | PC-3 cells, A431 cells, MCF-7 cells, pig brain tissue, MKN-45 cells, SGC-7901 cells |
| Positive IHC detected in | human breast cancer tissue, human colon tissue, rat colon tissue, rat stomach tissue Note: suggested antigen retrieval with TE buffer pH 9.0; (*) Alternatively, antigen retrieval may be performed with citrate buffer pH 6.0 |
| Positive IF-P detected in | human breast cancer tissue, human kidney tissue, mouse kidney tissue |
| Positive IF-Fro detected in | mouse brain tissue |
| Positive IF/ICC detected in | MCF-7 cells, mouse breast cancer, HaCaT cells |
推荐稀释比
| 应用 | 推荐稀释比 |
|---|---|
| Western Blot (WB) | WB : 1:2000-1:8000 |
| Immunohistochemistry (IHC) | IHC : 1:1000-1:4000 |
| Immunofluorescence (IF)-P | IF-P : 1:200-1:800 |
| Immunofluorescence (IF)-FRO | IF-FRO : 1:200-1:800 |
| Immunofluorescence (IF)/ICC | IF/ICC : 1:200-1:800 |
| It is recommended that this reagent should be titrated in each testing system to obtain optimal results. | |
| Sample-dependent, Check data in validation data gallery. | |
产品信息
60335-1-Ig targets E-cadherin in WB, IHC, IF/ICC, IF-P, IF-Fro, ELISA applications and shows reactivity with human, mouse, rat, pig samples.
| 经测试应用 | WB, IHC, IF/ICC, IF-P, IF-Fro, ELISA Application Description |
| 文献引用应用 | WB, IHC, IF |
| 经测试反应性 | human, mouse, rat, pig |
| 文献引用反应性 | human, mouse, rat, pig, canine, monkey |
| 免疫原 |
CatNo: Ag15085 Product name: Recombinant human E-cadherin protein Source: e coli.-derived, PET28a Tag: 6*His Domain: 373-622 aa of BC141838 Sequence: PIFNPTTYKGQVPENEANVVITTLKVTDADAPNTPAWEAVYTILNDDGGQFVVTTNPVNNDGILKTAKGLDFEAKQQYILHVAVTNVVPFEVSLTTSTATVTVDVLDVNEAPIFVPPEKRVEVSEDFGVGQEITSYTAQEPDTFMEQKITYRIWRDTANWLEINPDTGAISTRAELDREDFEHVKNSTYTALIIATDNGSPVATGTGTLLLILSDVNDNAPIPEPRTIFFCERNPKPQVINIIDADLPPI 种属同源性预测 |
| 宿主/亚型 | Mouse / IgG2b |
| 抗体类别 | Monoclonal |
| 产品类型 | Antibody |
| 全称 | cadherin 1, type 1, E-cadherin (epithelial) |
| 别名 | 6B11F11, Arc 1, Cadherin 1, Cadherin-1, CAM 120/80 |
| 计算分子量 | 882 aa, 97 kDa |
| 观测分子量 | 120 kDa |
| GenBank蛋白编号 | BC141838 |
| 基因名称 | E-cadherin |
| Gene ID (NCBI) | 999 |
| RRID | AB_2881444 |
| 偶联类型 | Unconjugated |
| 形式 | Liquid |
| 纯化方式 | Protein A purification |
| UNIPROT ID | P12830 |
| 储存缓冲液 | PBS with 0.02% sodium azide and 50% glycerol, pH 7.3. |
| 储存条件 | Store at -20°C. Stable for one year after shipment. Aliquoting is unnecessary for -20oC storage. |
背景介绍
Cadherins are a family of transmembrane glycoproteins that mediate calcium-dependent cell-cell adhesion and play an important role in the maintenance of normal tissue architecture. E-cadherin (epithelial cadherin), also known as CDH1 (cadherin 1) or CAM 120/80, is a classical member of the cadherin superfamily which also include N-, P-, R-, and B-cadherins. E-cadherin is expressed on the cell surface in most epithelial tissues. The extracellular region of E-cadherin establishes calcium-dependent homophilic trans binding, providing specific interaction with adjacent cells, while the cytoplasmic domain is connected to the actin cytoskeleton through the interaction with p120-, α-, β-, and γ-catenin (plakoglobin). E-cadherin is important in the maintenance of the epithelial integrity, and is involved in mechanisms regulating proliferation, differentiation, and survival of epithelial cell. E-cadherin may also play a role in tumorigenesis. It is considered to be an invasion suppressor protein and its loss is an indicator of high tumor aggressiveness.
实验方案
| Product Specific Protocols | |
|---|---|
| IF protocol for E-cadherin antibody 60335-1-Ig | Download protocol |
| IHC protocol for E-cadherin antibody 60335-1-Ig | Download protocol |
| WB protocol for E-cadherin antibody 60335-1-Ig | Download protocol |
| Standard Protocols | |
|---|---|
| Click here to view our Standard Protocols |
发表文章
| Species | Application | Title |
|---|---|---|
Adv Mater Glycated ECM Derived Carbon Dots Inhibit Tumor Vasculogenic Mimicry by Disrupting RAGE Nuclear Translocation and Its Interaction With HMGB1 | ||
Theranostics FSH induces EMT in ovarian cancer via ALKBH5-regulated Snail m6A demethylation | ||
Theranostics Vitamin D binding protein (VDBP) hijacks twist1 to inhibit vasculogenic mimicry in hepatocellular carcinoma | ||
Biomaterials Urinary exosomes-based Engineered Nanovectors for Homologously Targeted Chemo-Chemodynamic Prostate Cancer Therapy via abrogating IGFR/AKT/NF-kB/IkB signaling. |